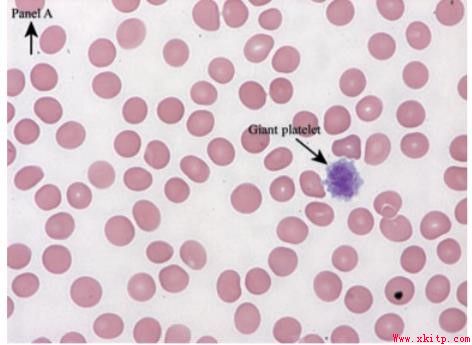
你以为的免疫性血小板减少症

第61届美国血液学会(ASH)年会于2019年12月7日至10日在美国奥兰多举行。每年一度的ASH年会是全球血液学领域规模最大、涵盖最全面的国际学术盛会之一,汇聚该领域最
352
ATRA联合HD-DXM治疗成人免疫性血
难治性免疫性血小板减少症
免疫性血小板减少症(immunethrombocytopenia,ITP)是除化疗外导致获得性血小板减少的最常见病因,大部分患者,包括慢性ITP患者,经传统治疗后预后良好,但有一小部分患
274
你以为的免疫性血小板减少症
2013年EuropeanJournalofHaematology报道过一个病例,一个21岁的女性,从两岁开始无明显诱因出现血小板减少,基础血小板值在5~15×109/L,却并没有出血症状。营养性、
228 [组图]轻松应对化疗所致血小板减少症">
[组图]轻松应对化疗所致血小板减少症">
[组图]轻松应对化疗所致血小板减少症
肿瘤化疗相关性血小板减少症(CIT)是指抗肿瘤化疗药物对骨髓巨核细胞产生抑制作用,导致外周血中血小板计数低于100×109/L。一、容易导致CIT的药物CIT发生与化疗药物
506
肝硬化并发血小板减少的原因和治
血小板减少是重症患者常见的并发症。在临床上,约70%的肝硬化患者伴有血小板减少。欧美国家惯例通常将血小板计数<150×109/L定义为血小板绝对减少。而因为中国人群
804医院介绍

河北无极血康中医医院中医血液病专科,2006年8月被石家庄市市政府主管部门指定为“城镇职工基本医疗保险”定点单位。2018年底我院升级为中医二级医院,为医保定点医院…【详细】
最新资讯
- 胡豫教授:勇攀出凝血疾病诊治高峰
- 侯明教授-成人ITP的最新诊疗策略!
- 肿瘤治疗所致血小板减少症诊疗指南(2022)
- 血小板减少性紫癜的西医治疗、疾病详述
- 血小板减少患者血栓形成的处理
- [推荐]·促进血小板生成治疗血小板减少
- 新冠疫苗诱导的免疫性血栓性血小板减少症(VIT
- 免疫性血小板减少症的院内管理
- 新冠疫苗诱导的免疫性血栓性血小板减少症(VIT
- 血小板减少疾病研究进展 2022第二届中国血液学